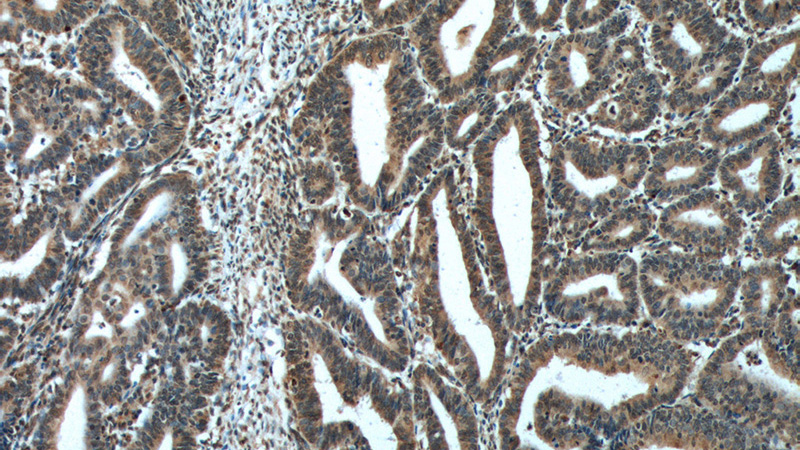
Immunohistochemistry of paraffin-embedded human endometrial cancer tissue slide using Catalog No:107490(PTEN Antibody) at dilution of 1:200 (under 10x lens). heat mediated antigen retrieved with Tris-EDTA buffer(pH9).
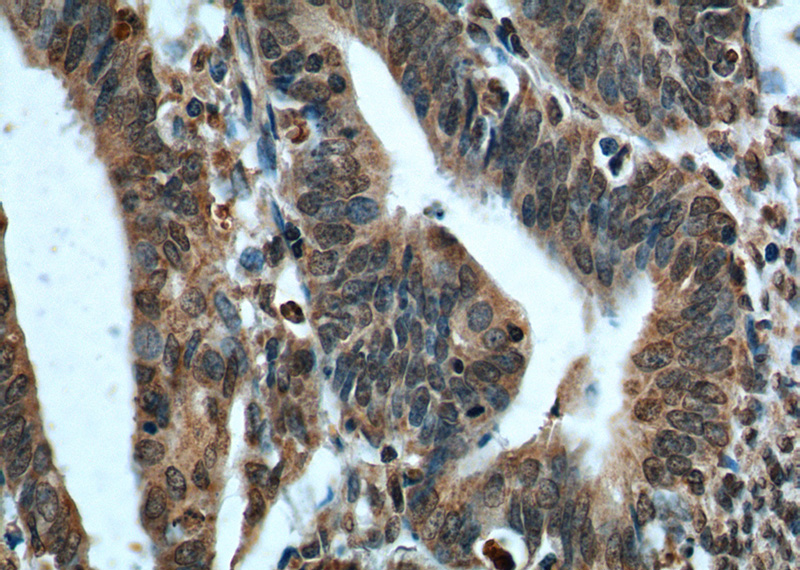
Immunohistochemistry of paraffin-embedded human endometrial cancer tissue slide using Catalog No:107490(PTEN Antibody) at dilution of 1:200 (under 40x lens). heat mediated antigen retrieved with Tris-EDTA buffer(pH9).

-
Product Name
PTEN antibody
- Documents
-
Description
PTEN Mouse Monoclonal antibody. Positive IF detected in HepG2 cells. Positive IHC detected in human endometrial cancer tissue, human breast cancer tissue, human breast hyperplasia tissue, human prostate hyperplasia tissue. Positive WB detected in DU 145 cells, fetal human brain tissue, HeLa cells, RAW 264.7 cells. Observed molecular weight by Western-blot: 55 kDa
-
Tested applications
ELISA, WB, IF, IHC
-
Species reactivity
Human, Mouse; other species not tested.
-
Alternative names
10q23del antibody; BZS antibody; MHAM antibody; MMAC1 antibody; phosphatase and tensin homolog antibody; PTEN antibody; PTEN1 antibody; TEP1 antibody
-
Isotype
Mouse IgG2a
-
Preparation
This antibody was obtained by immunization of PTEN recombinant protein (Accession Number: NM_000314). Purification method: Protein A purified.
-
Clonality
Monoclonal
-
Formulation
PBS with 0.02% sodium azide and 50% glycerol pH 7.3.
-
Storage instructions
Store at -20℃. DO NOT ALIQUOT
-
Applications
Recommended Dilution:
WB: 1:500-1:5000
IHC: 1:20-1:200
IF: 1:20-1:200
-
Validations

DU 145 cells were subjected to SDS PAGE followed by western blot with Catalog No:107490(PTEN Antibody) at dilution of 1:1000
Immunohistochemistry of paraffin-embedded human endometrial cancer tissue slide using Catalog No:107490(PTEN Antibody) at dilution of 1:200 (under 10x lens). heat mediated antigen retrieved with Tris-EDTA buffer(pH9).
Immunohistochemistry of paraffin-embedded human endometrial cancer tissue slide using Catalog No:107490(PTEN Antibody) at dilution of 1:200 (under 40x lens). heat mediated antigen retrieved with Tris-EDTA buffer(pH9).

Immunofluorescent analysis of HepG2 cells using Catalog No:107490(PTEN Antibody) at dilution of 1:50 and Alexa Fluor 488-congugated AffiniPure Goat Anti-Mouse IgG(H+L)
-
Background
PTEN (also designated MMAC1), products of tumor suppressor genes, are found deleted in most human gliomas. The PTEN genes are also mutated in many other tumors, such as brain, breast, kidney and prostate cancers. PTEN is a protein tyrosine phosphatase that may terminate the signaling transduction pathways mediated by PI 3-kinase/Akt. PTEN has an apparent molecular weight of 55 kDa and it is located in the cytosol.
-
References
- Wen W, Ding J, Sun W. Cyclin G1-mediated epithelial-mesenchymal transition via phosphoinositide 3-kinase/Akt signaling facilitates liver cancer progression. Hepatology (Baltimore, Md.). 55(6):1787-98. 2012.
- Liu S, Li L, Zhang Y. The oncoprotein HBXIP uses two pathways to up-regulate S100A4 in promotion of growth and migration of breast cancer cells. The Journal of biological chemistry. 287(36):30228-39. 2012.
- Liu J, Xu D, Wang Q, Zheng D, Jiang X, Xu L. LPS induced miR-181a promotes pancreatic cancer cell migration via targeting PTEN and MAP2K4. Digestive diseases and sciences. 59(7):1452-60. 2014.
- Wu Q, He J, Mei W, Zhang Z, Wu X, Sun F. Arene ruthenium(ii) complex, a potent inhibitor against proliferation, migration and invasion of breast cancer cells, reduces stress fibers, focal adhesions and invadopodia. Metallomics : integrated biometal science. 6(12):2204-12. 2014.
- Ying H, Qu D, Liu C. Chemoresistance is associated with Beclin-1 and PTEN expression in epithelial ovarian cancers. Oncology letters. 9(4):1759-1763. 2015.
Related Products / Services
Please note: All products are "FOR RESEARCH USE ONLY AND ARE NOT INTENDED FOR DIAGNOSTIC OR THERAPEUTIC USE"
